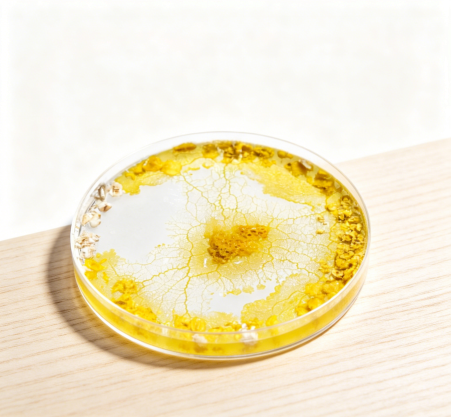
49B1A

自制回转仪探究微重力环境下植物及微生物的生长特点
1.徐州一中综合实践活动(研究性学习)课题实施方案申报表
课题名称 |
自制回转仪探究微重力环境下植物及微生物的生长特点 |
||||
课 题 组 成 员 及 有关 情况 |
姓名 |
性别 |
班级 |
职务 |
学号 |
韩长征 |
男 |
高一11 |
组长 |
||
王子诚 |
男 |
高一11 |
组员 |
||
胡凌赫 |
男 |
高一11 |
组员 |
||
指导教师 |
张雅轩 |
||||
课 题 研 究 的 目 的 及 主 要 内 容 |
目的: 通过大件和控制微重力模拟装置,学习微重力环境的科学原理及Arduino的控制技术,提升创新思维和工程应用素养 主要内容: 课题一:基于Arduino搭建微重力模拟装置 课题二:回转器模拟不同重力环境对水萝卜生长特性的影响 课题三:回转器模拟不同重力对钢丝绒菌生长特性的影响 |
||||
研究 假设 |
植物在微重力(太空/空间站)环境下,形态、方向、细胞、生理、繁殖都会发生明显改变,整体能存活但生长模式与地球差异很大 。 |
||||
研究 方法 |
实验、查找资料。 |
||||
研 究 步 骤 (各 阶 段 的 主 要 内 容 和 时 间 安 排) |
一 、8月22日-8月25日 领取科学盒子和科学海报 录制开箱视频,拍摄开箱照片 二、8月26日-8月27日 领取姓名专属条码,加入课题微信群、组建课题小组,参加课题群科学第一课 ,检查物资。 三、8月29日-9月10日 1. 登录在线学习平台 2. 完成探究性学习导论,合作讨论课程学习; 3. 完成先备知识课程学习和课题任务的节点任务提交; 4. 完成实验探究的课程学习和课题任务的节点任务提交; 5. 利用科探方舟盒子完成课题探究实验。 四、9月11日-9月12日 1.进行课题研究进展汇报 2.成果制作指导课程学习 五、9月13日-9月18日 成果制作和修改 六、9月14日-9月28日 1. 科学海报评选 2. ppt 预答辩 3. 科技论文评选 七、9月底 闭幕式,进行成果的汇报与表彰 |
||||
成果 形式 |
PPT,论文 |
||||
论 证 小 组 意 见 |
论证人签名: 年月日 |
||||
2.徐州一中综合实践活动(研究性学习)记录表
课题题目:自制回转仪探究微重力环境下植物及微生物的生长特点 |
编号: |
|
活动日期:9月20日 |
实验时间:8:00 |
|
指导教师:张雅轩 |
班级:高一11班 |
|
参加活动成员: 韩长征,王子诚,胡凌赫 |
||
课题一活动内容: 1)目的(解决什么问题): 微重力研究是空间生命科学的核心领域,兼具重要的科学价值与应用前景。从基础科学层面,它聚焦于解析重力作为环境信号对生命系统的调控机制,涵盖细胞骨架重塑、基因表达调控、代谢通路重构等关键科学问题,为揭示生命本质提供独特视角。在航天应用领域,研究成果直接服务于航天员长期驻留的健康保障,包括骨丢失、肌肉萎缩等航天疾病的防护与治疗,同时支撑空间生命支持系统的构建,为空间站及深空探测任务提供食物、氧气循环等关键技术。此外,微重力环境还为材料科学、制药工程等领域的创新提供了独特平台,推动地面相关产业的技术升级。 2)形式(小组讨论、试验、查阅资料、调查、实地测量): 实验、查阅资料、小组讨论。 3)过程: ①各自在家进行试验 ②小组展示、讨论各自的实验及结果 ③查阅资料,形成共识。 4)结果(得到什么结论、解决哪些问题、是否完成预定目标和计划、出现的新问题) 结论:对植物的影响:主要表现为根的生长方向,苗的高度,苗的损害程度和导电性。对细菌的影响:与正常重力环境相比,其他重力环境的绒泡菌长势更好,其中,转速环境中绒泡菌的爬行范围最远,形成原质团面积最大,这表明这一重力环境更有利于促进钢丝绒泡菌的生长 实验新问题:没有高精度的显微镜,未能研究其微观变化,实验对象种类较少,不具有普遍性 记录者:韩长征 |
||
注:1、由课题组长指派专人负责填写,备追踪课题研究过程时使用。
2、本表一式三份,交由年级处、指导教师、课题组长存档。
3.徐州一中综合实践活动(研究性学习)课题研究成果报告
题目:自制回转仪探究微重力环境下植物及微生物的生长特点 |
编号: |
|||||
课题组成员 |
组长:韩长征 |
组员:王子诚,胡凌赫 |
||||
指导教师:张雅轩 |
报告执笔人: 韩长征 |
完成时间:9月28日 |
||||
主导课程:微重力 |
相关课程:物理,生物 |
|||||
(一)书面材料 |
||||||
课题成果: 1)预期的成果: 三个课题均成功,符合预定推测。 2)课题实际取得的成果: 00001.实验一结果:成功搭建可运行的微重力模拟装置,实现预设的3种微重力场景模拟; 实验二结果:完成全部核心目标:成功搭建回转器重力模拟系统,完成3组重力梯度(正常重力、微重力、超重力)下的水萝卜培养实验,获取完整生长数据; 实验三结果:钢丝绒泡菌对模拟微重力环境的响应与植物存在显著差异,整体表现为模拟微重力环境促进其生长,且存在最优转速区间 |
||||||
00001.参考书目及资料: 00002.实验设计阶段:参考《南师附中江宁分校科学盒子项目微重力课题》的实验设计,结合《水萝卜栽培环境特点》优化实验条件控制 00003.实验操作阶段:以《微重力环境下生物实验技术-洞察及研究》为操作指南,确保回转器运行稳定、样本处理规范 00004.数据分析阶段:依据《植物生理学实验技术》中的方法进行数据处理和统计学分析,结合《空间植物栽培技术研究进展》的理论解读实验结果 |
||||||
附录材料(要求提交原始记录)包括: 活动记录表(1)份 访谈表()份 实验记录(1)份 调查表()份 测量数据记录(1)份 |
||||||
(二)实物材料,如制作的图片,模型,照片,事物样本,音像资料等 编号: 名称: 制作者: 内容: 功能: |
||||||
(三)演示课题成果所需要的条件,要求(如特别需要,请说明): |
||||||
4.自制回转仪探究微重力环境下植物及微生物的生长特点
徐州市第一中学高一11班韩长征,王子诚,胡凌赫
【摘要】
为探究微重力环境对生物生长发育的影响,本研究采用自制回转仪模拟不同程度的微重力环境,以水萝卜(Raphanus sativus L.)为研究对象,设置0(CK)、56.63(MO)、85.76(MA)、139.43(EA)r/min四个转速梯度,分析不同重力条件下植物根系生长结果表明:随着回转仪转速升高,水萝卜根系长度显著降低,相对电导率和伤害度显著升高;此外用回转器模拟不同重力环境对刚丝绒泡菌生长特性的影响,研究结果为深入理解微重力环境对黏菌生长的影响机制提供了实验依据,同时验证了自制回转仪在模拟微重力环境中的有效性。
【关键词】
微重力,舵机,回转率,导电率,伤害率
一、研究背景
微重力实验的核心背景
1. 空间探索的刚需驱动
随着人类航天事业的发展,长时间空间驻留成为现实(国际空间站已实现常年载人),但微重力环境对生物体的影响尚未完全明确。研究微重力下生物的生长特性,是保障航天员健康、实现星际移民和空间资源开发的基础。
·航天员长期驻留太空会出现骨密度流失、肌肉萎缩、免疫系统紊乱等问题
·空间生物培养可为空间站提供食物、氧气和循环再生系统
·微重力环境为研究生命本质和进化提供了独特的实验平台
2. 地面模拟技术的成熟
由于空间实验成本高、机会有限,地面模拟微重力技术成为重要替代方案。回转仪(也称为回转器、clinostat)是目前应用最广泛的模拟装置,通过持续旋转使生物体受到的重力矢量平均为零,从而模拟微重力环境。
·回转仪技术已被广泛应用于植物、微生物、动物细胞等多种生物的研究
·研究表明,回转仪模拟的微重力环境与真实太空环境对生物的影响具有高度相关性
·自制回转仪成本低、操作简单,适合开展基础研究和教学实验
3. 黏菌研究的独特价值
刚丝绒泡菌作为黏菌的代表,具有独特的生物学特性:
·是一种介于真菌和原生动物之间的真核生物,兼具单细胞和多细胞的特征
·具有复杂的行为模式,如趋光性、趋化性、网络形成等
·细胞结构简单,易于观察和操作,是研究细胞骨架、细胞周期和信号转导的理想模型
·黏菌在生态系统中扮演着重要的角色,研究其对微重力的响应有助于理解极端环境下的生态适应性
00002.
00003.实验一、成功搭建可运行的微重力模拟装置,实现预设的3种微重力场景模拟;
00001.实验二、深入理解植物对微重力环境的响应机制,完善植物重力信号转导理论,为空间生物学研究提供实验依据
实验三、研究结果为深入理解微重力环境对黏菌生长的影响机制提供了实验依据,同时验证了自制回转仪在模拟微重力环境中的有效性。
二、实验材料与仪器
微重力装置、培养皿、记号笔(自备)、琼脂、电子秤、称量纸、药匙、搅拌棒、刚丝绒泡菌套装(刚丝绒泡菌、燕麦、滴管、镊子)、泡棉胶带、滤纸、迷宫模型、电煮锅(自备)、剪刀(自备)、手机(自备)、电脑(自备)、透明胶带(自备)、微波炉(自备)、烧杯、自来水(自备)、拍摄参照物(自备)
三、研究过程
课题一活动内容:
目的(解决什么问题):
通过大件和控制微重力模拟装置,学习微重力环境的科学原理及Arduino的控制技术,提升创新思维和工程应用素养
过程:
1.组装回转仪核心部件,连接Arduino主板、传感器与电机,调试硬件通信;
2.编写控制程序,设置0(CK)、56.63(MO,月球重力)、85.76(MA,火星重力)、139.43(EA,高转速模拟)r/min四个转速梯度,测试旋转平台的稳定性;
3.优化装置结构,解决旋转平台晃动问题,确保实验样本固定牢固;
4.连续运行装置,测试其长期工作状态,记录故障与问题。
结果(得到什么结论、解决哪些问题、是否完成预定目标和计划、出现的新问题)
00001.①解决的问题:搞定了Arduino和传感器、电机的同步通信问题,让各部件能顺畅配合;解决了装置小却容易晃的问题,用轻量支架和结构优化,让运行更稳。
00004.②目标完成情况:完成预定核心目标:成功搭建可运行的微重力模拟装置,实现预设的3种微重力场景模拟;
③出现的新问题:装置连续运行超过2小时后,Arduino主板出现轻微发热现象,
可能影响长期稳定性;
课题二活动内容:
目的(解决什么问题):
探究不同重力环境对水萝卜根系生长、植物损害程度,分析重力梯度与植物细胞活性的关联。
自变量:回转器不同转速(0、56.63、85.76、139.43 r/min)、旋转培养时长;
因变量:水萝卜发芽率、根系生长方向、根系长度、相对电导率、伤害度;
无关变量:培养温度、光照、培养基湿度、种子初始状态(统一消毒、筛选)。
过程:
1.水萝卜种子预处理:挑选饱满种子,进行消毒处理,播种于MS培养基的培养皿中;
2.分组培养:将培养皿分别固定在回转仪不同旋转平台,设置对应转速,对照组(CK)置于正常重力环境下,相同条件培养;
3.定期观测:24h、48h记录种子发芽率与根系生长方向,连续培养7d,每天观测根系生长状态,实验结束后测定根系长度、相对电导率与伤害度;
4.数据采集:制作根系切片(初步观察),记录各项生理指标,整理成数据表格。
结果(得到什么结论、解决哪些问题、是否完成预定目标和计划、出现的新问题)
发芽率与根系方向:随着转速升高,水萝卜发芽率逐渐降低,根系生长方向从垂直向下逐渐变为水平甚至随机方向;24h时对照组发芽率65-75%,高转速组(EA)仅50-60%,48h后各组发芽率均提升,但组间差异保持不变;
根系长度:7d培养后,根系长度随转速升高显著降低,对照组平均根系长度12.175cm,月球重力组(MO)9.825cm,火星重力组(MA)6.375cm,高转速组(EA)仅3.474cm;
相对电导率与伤害度:相对电导率随转速升高呈上升趋势,对照组67.2%,高转速组79.5%;植物伤害度与转速正相关,高转速组伤害度达31.4%,表明细胞膜完整性随重力环境模拟程度的增强而降低;
整体生长特性:微重力环境下水萝卜株高较正常重力组增加约20%,但主根长度缩短约20%,侧根数量减少约35%,呈现“地上部分徒长、地下根系抑制”的生长特征;
目标完成与未完成说明:完成核心目标,搭建了回转器重力模拟系统,完成3组重力梯度下的水萝卜培养实验,获取完整生长数据;原计划开展种子萌发阶段的重力响应实验,因种子发芽率低于预期且旋转下固定不牢,仅完成幼苗期实验;
新问题:实验仅持续28天,未覆盖水萝卜全生长周期,长期重力环境对其开花、结果等生殖生长的影响仍需研究;舵机发热问题影响实验的连续开展。
实验设计表 |
|||
处理编号 |
模拟环境 |
重力加速度(m/s) |
回转器转速(r/min) |
1:CK |
对照 |
9.8 |
0 |
2:MO |
月球 |
1.62 |
56.63 |
3:MA |
火星 |
3.71 |
85.76 |
4:EA |
地球 |
9.8 |
139.43 |
观测时间 |
实验组编号 |
回转器转速(r/min) |
发芽率(%) |
根系生长方向 |
24h |
1:CK |
0 |
65-75% |
垂直向下生长 |
2:MO |
56.63 |
60-70% |
与垂直线成一定角度倾斜生长 |
|
3:MA |
85.76 |
55-65% |
与垂直线成一定角度倾斜生长 |
|
4:EA |
139.43 |
50-60% |
近水平生长,部分呈随机方向 |
|
48h |
1:CK |
0 |
85-95% |
垂直向下生长,主根伸长明显 |
2:MO |
56.63 |
75-85% |
倾斜角度稳定,侧根开始萌发 |
|
3:MA |
85.76 |
70-80% |
倾斜角度进一步增大,根系向四周扩散 |
|
4:EA |
139.43 |
65-75% |
水平生长为主,部分根系出现缠绕 |
00002.
回转器不同旋转速度下的植物根系长度数据记录表 |
||||||
生长周期:7d(按照实际天数填写) |
测定指标:根系长度(L/cm)(如测定其他根系指标,则修改为其他指标) |
|||||
实验组编号 |
回转器转速(r/min) |
种子编号(按照实际数量填写) |
平均值 |
|||
1 |
2 |
3 |
4 |
|||
1:CK |
0 |
12.5 |
11.8 |
12.2 |
12.2 |
12.175 |
2:MO |
56.63 |
9.8 |
10.2 |
9.5 |
9.8 |
9.825 |
3:MA |
85.76 |
6.3 |
6.7 |
6.1 |
6.4 |
6.375 |
4:EA |
139.43 |
3.5 |
3.2 |
3.7 |
3.5 |
3.474 |
回转器不同旋转速度下的植物电导率数据记录表 |
|||||||||||
实验组编号 |
回转器转速(r/min) |
R0: |
相对电导率(%) |
||||||||
R1: |
R2: |
||||||||||
1 |
2 |
3 |
均值 |
1 |
2 |
3 |
均值 |
||||
1:CK |
0 |
12.5 |
12.8 |
12.3 |
12.5 |
38.2 |
37.9 |
38.5 |
38.2 |
67.2 |
|
2:MO |
56.63 |
13.1 |
12.9 |
13.3 |
13.1 |
45.6 |
46.1 |
45.2 |
45.6 |
71.3 |
|
3:MA |
85.76 |
13.8 |
14.1 |
13.6 |
13.8 |
52.3 |
51.8 |
53.0 |
52.4 |
75.6 |
|
4:EA |
139.43 |
14.5 |
14.3 |
14.7 |
14.5 |
60.1 |
61.2 |
59.8 |
60.4 |
79.5 |
|
回转器模拟不同重力环境水萝卜的生长特性分析表 |
||||
实验组编号 |
回转器转速(r/min) |
根系长度(cm) |
相对电导率(%) |
伤害度(%) |
1:CK |
0 |
8.2 |
62.5 |
0.0 |
2:MO |
56.63 |
6.5 |
68.3 |
9.3 |
3:MA |
85.76 |
4.2 |
75.6 |
21.0 |
4:EA |
2139.43 |
2.8 |
82.1 |
31.4 |
课题三、回转器模拟不同重力对钢丝绒菌生长特性的影响
研究目的:
分析不同模拟重力环境对钢丝绒泡菌原质团形成、爬行范围、生长态势的影响,探究微生物对微重力的适应机制。
实验过程:
1.钢丝绒泡菌培养:配置琼脂培养基,接种钢丝绒泡菌,25°C黑暗培养,原质团形成后每天加入湿润燕麦作为营养源;
2.分组处理:将培养皿固定在回转仪不同转速平台,设置与植物实验相同的转速梯度,对照组置于正常重力环境;
3.指标观测:每天拍照记录原质团生长状态,采用“+++(很远)、++(较远)、+(几乎无)”标记爬行范围;
4.数据测定:将实验照片上传电脑,用ImageJ软件测定原质团面积,对比不同实验组的生长差异;
5.行为观察:观察不同重力环境下钢丝绒泡菌在迷宫模型中的觅食效率与路径选择。
结果(得到什么结论、解决哪些问题、是否完成预定目标和计划、出现的新问题)
钢丝绒泡菌对模拟微重力环境的响应与植物存在显著差异,整体表现为模拟微重力环境促进其生长,且存在最优转速区间:
1.与正常重力相比,旋转模拟的微重力环境下,绒泡菌的爬行范围更广、原质团面积更大,表明微重力环境更适合其生长繁殖,推测原因是微重力环境降低了其细胞运动的阻力,或调控了其代谢与增殖相关的生理过程;
2.过高转速会对绒泡菌生长产生抑制作用,说明微生物对重力环境的适应存在阈值,超出阈值的外部环境会成为胁迫因子,影响其正常生长;
3.微重力环境能提升绒泡菌的迷宫觅食效率,表明其可通过调整行为模式与生理机制适应不同的重力环境,体现了微生物对极端环境的较强适应性。
四.总结
1.本研究成功搭建了基于Arduino的自制回转仪,该装置可稳定实现不同转速梯度的控制,有效模拟不同重力环境,满足中学微重力生物探究实验的基本需求,验证了自制回转仪的实用性与有效性;
2.模拟微重力环境对水萝卜生长特性具有显著影响,呈现地上徒长、地下抑制的器官特异性特征,且随转速升高(重力模拟程度增强),水萝卜发芽率降低、根系生长方向紊乱、根系长度缩短,伤害度升高,各项指标均呈现明显的重力梯度效应;
3.模拟微重力环境整体对钢丝绒泡菌的生长具有促进作用,使其爬行范围更广、原质团面积更大,且适当的微重力环境能提升其觅食效率;微生物对重力环境的适应存在最优转速区间,过高转速会产生抑制作用,钢丝绒泡菌可通过调整营养获取、代谢活动和信号传递模式适应不同重力环境;
4.植物与微生物对模拟微重力环境的响应存在显著差异,植物的生长发育受微重力环境的抑制(根系)或异常调控(地上部分),而微生物更适应微重力环境,这种差异与两者的细胞结构、生长方式和重力感知机制相关。
五.参考资料
1.《南师附中江宁分校科学盒子项目微重力课题》
2.《水萝卜栽培环境特点》
3.《微重力环境下生物实验技术-洞察及研究》
4.《植物生理学实验技术》
5.《空间植物栽培技术研究进展》
实验一相关图片

实验二相关图片



实验三相关图片